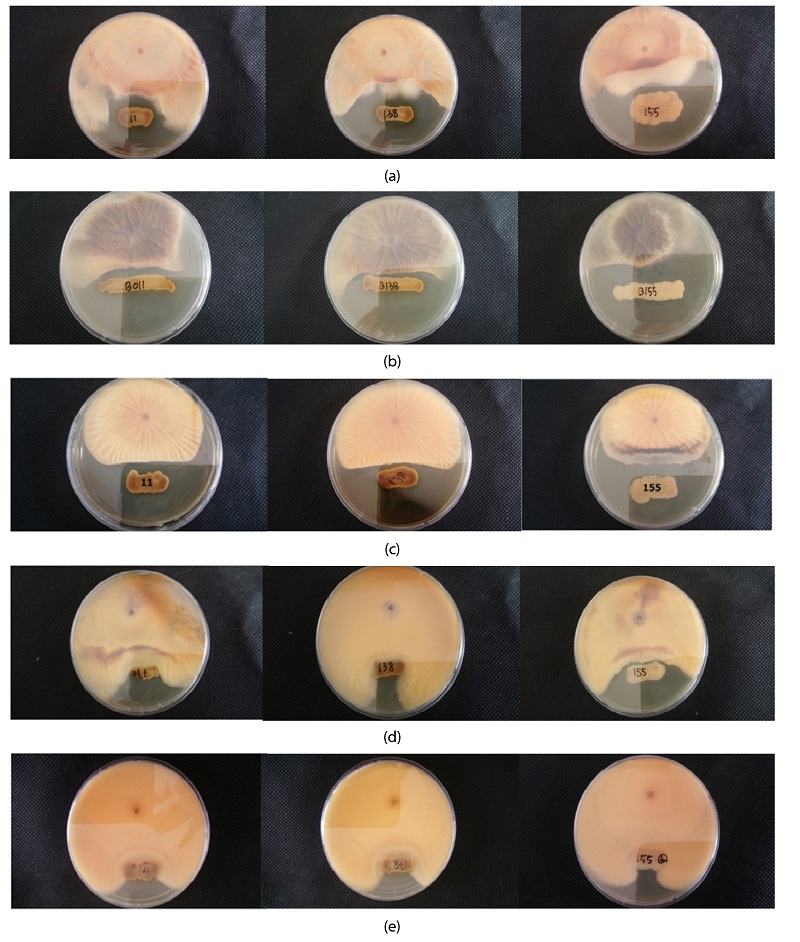
http://static.apub.kr/journalsite/sites/ksssf/2017-050-06/N0230500611/images/Figure_KSSSF_50_06_11_F1.jpg

Introduction
우리나라의 경제적 능력의 증가로 인해 안전한 먹거리에 대한 사회적 관심이 증대되었고, 화학비료 및 농약 사용에 따른 생태계 파괴, 잔류독성 및 약해 문제 등에 대한 관심도 함께 증가하였다. 화학비료와 농약의 무분별한 사용으로 인해 생물농축의 문제가 야기되면서 친환경 농산물에 대한 수요가 증대되었다 (Chung and Chang, 2007). 전 세계의 요구에 따라 우리나라에서도 친환경 농산물의 수준을 3%에서 10%까지 증대시키는 것을 골자로 한 친환경농업 육성법이 1997년 입법화되었으며 화학비료와 농약의 사용량을 2013년 까지 40% 감축을 목표로 친환경 농업 관련 정책을 수행해 왔다. 이러한 정부 정책에 대한 노력의 일환으로 무분별한 농약사용을 대체하고자 친환경 유기농자재개발에 대한 지원이 꾸준히 이뤄지고 있는 추세이다 (Park, 2013; MIFAFF, 2009; KFDA, 2005; KEFAM, 2012). 친환경 유기농자재 중 병해충 관리 자재로 분류 할 수 있는 생물농약자재 중에서 특히 길항 미생물을 이용한 생물학적 방제제의 경우 1912년 Hartley가 Pythium debaryanum에 의한 소나무 유묘 잘록병 방지를 위해 길항 진균을 이용한 이후 현재 다양한 식물병원균 방제를 위해 활용되고 있다 (Hartley, 1912; Nam, 2006; Park, 2013). 미생물제재를 사용하는 주된 이유는 농약 및 화학적 비료 사용량을 줄이고 환경 친화적인 농업을 하기 위해서이다. 미생물 제재는 양분 공급, 양분 가용화 및 토양 특성 개량 등 다양한 목적에 의해 개발되고 있으며 실제 여러 농가에서 활발히 이용되고 있다 (Yang et al., 2008). 또한 길항미생물에서 발견되는 항생 및 항균 물질 (Antibiotic) 은 한 종의 미생물이 생성하는 2차 대사산물로서 100 uL mL-1 또는 그 이하의 농도로 다른 미생물에게 확산되어 저해시키는 물질로 정의될 수 있다. 토양 근권 미생물의 경우 작물에 발병하는 병원균의 생장을 억제하거나 식물병 저항성을 유도하여 효과적으로 방제할 수 있으며, 근권 미생물의 주요 길항작용으로는 chitinases, lipases 및 proteaes 등과 같은 세포벽 분해효소를 2차적으로 생산함으로써 식물병원균을 억제하는 것으로 알려져 있다. 특히 항균물질을 생성하는 Bacillus subtilis의 경우 식물의 뿌리 부근에 서식하며 식물생장촉진 및 식물병 발생억제 등 많은 연구가 진행되고 있으며 Paenibacillus polymyxa의 경우 polymyxin이라는 항균물질을 생성한다는 연구보고가 있다 (Yang, 2011; Shaheen et al., 2011). 특히 인삼의 경우 대표적인 연작작물로써 4∼6년의 긴 재배기간과 가식부위가 지하부라는 특징으로 인해 가식부위에 식물 병원균이 발병할 경우 방제가 어렵다는 문제가 농가에서 제기 되고 있는 실정이다. 인삼과 같은 지하부에 가식부위가 존재하는 작물의 경우 특히 길항미생물을 이용하여 병원균의 발생을 억제하는 것이 매우 효과적인 것으로 여겨지고 있다. 따라서 본 연구는 인삼에 주로 발병하는 지하부 병원균 5 종에 대한 우수항균효과를 가지는 우수길항균주를 토양 근권으로부터 분리 및 동정하여 항균능력을 평가하는데 있다.
Materials and Methods
토양시료 채취 및 분석 본 연구에 사용된 토양시료의 경우 강원도 철원군 김화읍 청양리 276-4에 위치한 인삼약초연구소 인삼재배지 및 예정지의 서로 다른 4곳 (A: 인삼재배지 1, B: 인삼재배지 2, C: 인삼재배예정지 1, D: 인삼재배예정지 2)에서 근권토양을 채취하였고, 채취한 시료는 3일동안 풍건 후 2 mm체로 체거름하여 사용하였다. 공시시료의 이화학분석 항목으로는 pH, EC, 유효인산, NO3-N, 유기물함량, 양이온교환용량 (CEC), 양이온 함량, 토성을 측정하였으며, 토양 및 식물체 분석법 (NIAS, 2000)과 토양화학분석법 (NIAS, 2010)에 준하여 분석하였다 (Table 1).
Table 1. Physico-chemical properties of four soils used for experiment.

Soil Texture; A: SCL, B: SCL, C: SC, D: SCL
* SCL: Sandy Clay Loam, SC: Sandy Clay
근권길항균주 (토착미생물) 연구에 사용된 근권길항균주의 경우 인삼재배지 근권토양으로부터 희석평판법 (Dilution plate method)을 통해 분리하여 사용하였으며, 배양의 경우 Nutrient agar (NA, Difco, USA)배지를 사용하였다. 총 토양에서 분리된 균주 160 종은 순수분리를 통해 본 연구에 사용하였다.
토양전염성 병원균 5종 실험에 사용된 병원균 5 종 (Sclerotinia sclerotiorum, Fusarium solani, Collectotricum gloeosporides, Fusarium oxysporum, Botrytis cinerea)은 인삼 재배지에서 가장 발생 빈도수가 높은 지하부 병원균 5 종을 선정하였고, 농업유전자원정보센터 (The RDA-Genebank Information Center)로부터 분양 받아 Potato dextrose agar (PDA, Difco, USA) 사면배지 제조 후 계대배양하여 4°C에 저온보관 하여 본 연구에 사용하였다.
길항세균 및 식물병원균 배지조성 본 연구에 사용된 배지는 세균의 경우 Nutrient agar (NA: Beefextract 3.0 g, peptone 5.0 g, agar 15.0 g per 1000 mL D.W, pH 6.8)를 이용하였고, 곰팡이의 경우 Potato dextrose agar (PDA: Potato strach 4.0 g, dextrose 20.0 g, agar 15.0 g per 1000 mL D.W, pH 5.6)를 제조 하여 본 연구에 사용하였다.
근권미생물 분리 및 배양 본 연구에서 근권미생물을 분리하는 과정으로 먼저 토양시료 1 g과 멸균수 10 mL를 혼합하여 1 : 10 (w : v) 비율로 상온에서 30 분간 200 rpm 조건으로 회전식진탕기 (Jeiotech, KR/SK-600, Korea)로 교반하였고, 그 후 희석평판법을 이용하여 10-1 ~ 10-5 수준으로 희석배수에 맞춰 NA배지와 PDA배지에 도말하여 배양하였다. 보통 세균의 경우 NA배지에서 배양이 잘 되는 것을 확인할 수 있었으며, 곰팡이의 경우 PDA배지에 배양이 더욱 활성화 되는 것을 확인할 수 있었다. 배양된 토양미생물의 단일 colony를 백금이로 streaking하여 121°C 30 분간 멸균된 배지에 배양하였다. 세균의 경우 incubator (Sanyo, HK-BI025, Japan)를 이용하여 37°C에서 1~2일 동안 배양하였고, 곰팡이의 경우 상온조건에서 3~5일 동안 배양하여 각각의 미생물의 생장을 관찰하였다.
근권미생물 순수분리 근권세균의 길항능력을 평가하기 위하여 단일 세균을 분리하는 순수분리 과정을 진행하였고, 이는 단일 colony를 분리해내는 작업으로써 최종적으로 병원균의 활성검정능력을 확인할 수 있는 검정 중 하나이다. 희석배수에 맞춰 자란 임의의 세균 160종을 준비된 NA배지에 도말 및 접종하여 배양하였다.
식물병원균에 대한 길항능력 평가 식물병원균 5 종 (Sclerotinia sclerotiorum, Fusarium solani, Collectotricum gloeosporides, Fusarium oxysporum, Botrytis cinerea)에 대한 길항능력을 평가하기 위해 길항세균과 대치배양을 진행하였다. 병원균의 경우 PDA배지에 계대배양하여 암실조건의 항온기에서 24°C로 3 일간 배양하였다. 반복된 계대배양을 통해 1일간 더 배양하여 고활성 병원균을 확보하였으며, 이 후 PDA plate에 각각의 병원균을 접종 후 근권토양으로부터 분리된 160 종의 세균을 대치배양하였고, 그 중 식물병원균 5 종에 대해 모두 길항능력이 있는 균주를 선택하여 단일대치배양 과정을 통해 최종적으로 효과적인 길항균주를 선발하였다.
우수균주 16s rRNA 염기서열분석 생물학적 동정 토양에서 분리된 총 160종의 균주를 대치배양하여 선발된 길항우수균주 3 종을 대상으로 Gram staining method를 진행하였다. 16S rRNA 염기서열을 분석을 위해 프라이머는 universal primer인 27F (5'-AGAGTTTGATCCTGGCTCAG-3')와 1492R (5'-GGTTACCTTAGGACTT-3')를 사용하였고, DNA Engine Tetrad 2 Peltier Thermal Cycler (BIO-RAD, USA)로 유전자를 증폭하였다. 우수한 3 종의 균주의 정보를 파악하기 위하여 Bigdye(R) Terminator v3.1 sequencing kit (Applied Biosystems, USA)를 이용해 16S rRNA 염기서열을 확인하였으며, 미국국립생물정보센터 (National Center for Biotechnology Information)인 NCBI의 BLAST (Basic Local Alignment Search Tool) 데이터 베이스를 통해 각각의 균주의 분류를 파악 후 비교하였다.
Results and Discussion
근권길항균주 분리 토양으로부터 근권미생물을 분리한 결과 160 종의 세균이 확인되었고, 토양 채취 지점 대부분의 세균이 근권균주로 확인되었다. 선행연구에 따르면 근권미생물의 종류로는 Agrobacterium sp, Pseudomonas sp.이 대부분을 차지하고 있으며, 포자 형성균인 Bacillus sp.의 경우 일반적으로 적은 양이 존재하는 것으로 알려져 있다 (Kim et al., 2012). 본 연구에 사용된 토양 시료에서 분리된 세균의 경우 Agrobacterium sp, Pseudomonas sp, Bacillus sp.과 곰팡이 등 다양한 세균이 발견되었다. 이 중 Bacillus sp.의 경우 항균활성 기작이 발현되며, 항균물질을 생성해 병원균의 증식을 억제한다는 결과가 보고된 바 있다 (Rios et al., 1988). 또한 항균효능이 뛰어난 Burkholderia sp.의 균주도 많은 양이 존재하는 것으로 나타났으며 본 연구에서 분리된 Bacillus sp.의 일종인 Paenibacillus와 Burkholderia 종이 항균능력이 뛰어나 5 종의 병원균 증식을 억제하는 것으로 확인되었다. 이는 선행연구에서 제시한 결과와 거의 일치한 것으로 나타났다 (El-Banna and Winkelmann, 1998).
대치배양을 이용한 우수균주 선발 항균능력 우수균주를 선발하기 위하여 농업기술원 인삼약초시험장 인삼재배지 토양에서 분리된 160 종의 세균을 대치배양하여 지하부병을 유발하는 대표적인 병원균 Sclerotinia sclerotiorum, Fusarium solani, Collectotricum gloeosporides, Fusarium oxysporum, Botrytis cinerea에 대해 clear zone을 통한 병원균 증식을 저해하는 균주를 조사 하였다 (Chand and Kumar, 2015). 대치배양을 통하여 병원균의 증식을 저해하는 균주를 조사한 결과, 160 종의 균주 중 32 종의 균주가 병원균 증식 억제에 영향을 미치는 것으로 나타났다. 그 결과는 Table 2에 제시하였고, 32 종의 균주 중 3 종의 균주를 제외한 균주의 경우 병원균에 대하여 선택적으로 병원균 증식 억제에 영향을 미치는 것으로 평가 되었으며, 병원균이 자라지 않는 clear zone의 크기에 따라 각 균주의 억제 가능성을 평가 할 수 있었다. 선발된 균주 B (11, 138, 155)의 길항능력을 평가한 결과 모든 병원균의 증식 억제에 영향을 미치는 것으로 판단되어 최종적으로 3 종의 균주가 가장 길항능력이 높은 것을 확인할 수 있었으며, 우수 균주 3 종을 대상으로 식물병원균과 단일 대치배양을 수행한 결과 Fig. 1(a)~1(e)와 같은 경향이 관찰되었다.
Fig. 1.
Antifungal activities of 3 strains (B11: Burkholderia cepacia ATCC 25416, B138: Burkholderia cepacia ET 13, B155: Paenibacillus polymyxa ATCC 842) for five pathogenic fungi (a: Sclerotinia sclerotiorum, b: Botrytis cinerea, c: Colletotrichum gloeosporioides, d: Fusarium oxyporum, e: Fusarium solani).
염기서열 분석 및 생물학적 동정 식물병원균에 대해 길항효과가 입증된 균주 3 종에 대해 gram staining을 진행한 결과 길항균주 3 종 모두가 gram-postive로 나타났으며, 분자 생물학적 방법으로 얻어진 sequencing결과를 NCBI BLAST 데이터베이스를 통해 비교 ․ 분석한 결과, B11의 균주는 Burkholderia cepacia ATCC 25416으로 99% 일치하는 것으로 나타났으며, B138번의 경우 위와 균주는 동일하지만 Strain no.가 다른 ET 13으로 99% 일치하였다. B155번의 경우 Paenibacillus polymyxa ATCC 842로 99%로 일치하는 결과가 나왔다 (Table 3). 최종적으로 분리 및 동정된 3 종의 균주는 인삼 지하부 병원균 5 종에 대한 길항능력이 우수한 길항균주로 선발 되었다.
Conclusions
본 연구는 인삼재배지 근권토양 내 존재하는 우수길항균주를 통해 인삼 지하부병을 효율적으로 방제 할 수 있는 방안을 마련하기 위해 수행되었다. 채취한 토양에서 토양 미생물을 분리한 결과 총 160 종의 근권세균들이 확인 되었고, 그 중 우수 길항효과를 보인 Burkholderia 와 Paenibacillus 종을 확인할 수 있었다. 식물병원균 5 종과 대치배양한 결과 32 종의 균주중 3 종의 균주 (B11, B138, B155)는 식물병원균 (Sclerotinia sclerotiorum, Fusarium solani, Collectotricum gloeosporides, Fusarium oxysporum, Botrytis cinerea)에 대하여 증식을 저해시켜 병원균 증식 억제에 대한 효과를 입증하였으며, 16S rRNA 염기서열 분석을 토대로 NCBI BLAST프로그램데이터 베이스를 활용하여 최종적으로 3 종의 균주를 각각 분자 생물학적 방법으로 동정한 결과, Burkholderia cepacia ATCC 25416, ET 13 균주로 99% 일치하였고, Paenibacillus polymyxa ATCC 842로 99% 일치하는 것을 확인하였다. 본 연구에서는 근권토양에 존재하는 길항균주의 항균력 입증을 통해 토착 미생물을 이용한 생물학적 방제의 가능성을 확인하였으며, 작물 시험포장 및 포트시험을 통해 실질적인 길항효과검정을 진행예정에 있으며, 이는 농경지에서 발생하는 식물 병원균에 대한 효율적인 관리방안의 확보 및 기초 자료로 사용될 수 있을 것이다. 또한 농작물 재배 예정지역의 토양 내 식물병원균 정보를 제공한다면 농작물을 안정적으로 재배 ․ 생산할 수 있는 안전체계를 구축할 수 있을 것으로 사료된다.





